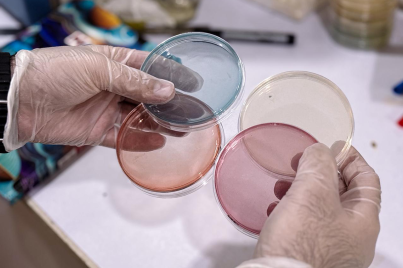

RTDC Gallery
Your health is our priority, therefore, we provide a wide range of health packages that include tests at discounted prices for your convenience, making them more cost-effective for you.
RTDC Gallery
Your health is our priority, therefore, we provide a wide range of health packages that include tests at discounted prices for your convenience, making them more cost-effective for you.